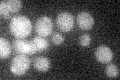
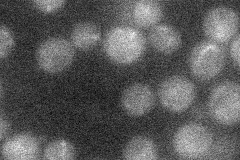

View description
GTP/GDP exchange factor for Rsr1p (Bud1p) required for both axial and bipolar budding patterns; mutants exhibit random budding in all cell types
Localization:
Intensity:
Fold change:
Significance:
-
C’ GFP library in SD
below threshold16.39 -
N' NOP1pr-GFP in SD
below threshold13.3919 -
N' TEF2pr-mCherry in SD

below threshold5.77686 -
N' NATIVEpr-GFP in SD

missing0 -
N' TEF2pr-VC and Cyto-VN in SD

#N/A0 -
C’ GFP library in SD+DTT

cytosol150.91No -
C’ GFP library in SD+H2O2

cytosol19.931.21No -
C’ GFP library in Starvation Media

cytosol17.351.05No -
C’ GFP library on the background of Pup2-DaMP

below threshold -
C’ GFP library on the background of CCT mutant

below threshold17.78381.08479No
